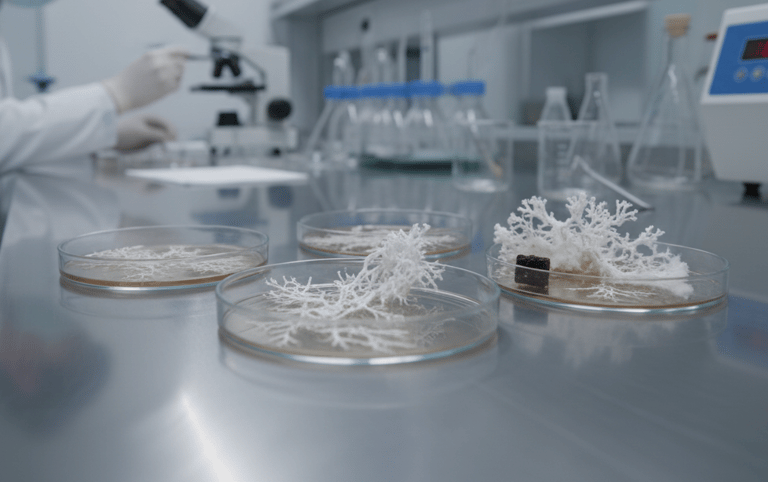
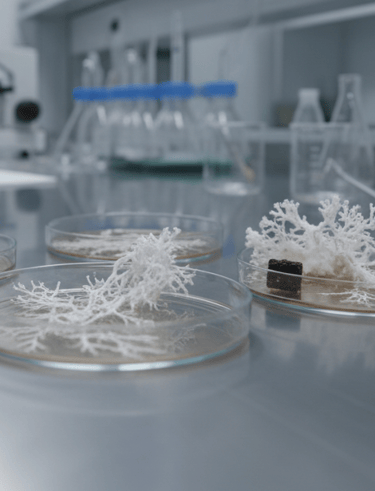

Mushroomspore's straight from the source.
Free shipping on orders over 150$


A Modern Approach to Mycology Our Educational Grow Kit is an innovative and engaging introduction to the world of botany and fungi. Crafted to facilitate hands-on learning, it offers a modern and thoughtfully designed way to explore the fascinating life cycle of mushrooms. Whether used for a biology project in the classroom or for private botanical research at home, this kit provides a professional window into the wonders of nature.
Quality and Reliability The Grow Kit combines ease of use, durable design, and premium quality in one refined product. Our substrates are formulated to work perfectly with our wide range of Spore Syringes and Spore Vials, delivering a consistent and reliable cultivation environment. The kit is prepared with the utmost care to ensure freshness, providing the optimal conditions for mycelium to thrive.
Simple and Approachable Designed with a user-friendly format, the Educational Grow Kit makes the cultivation process simple and approachable, eliminating common setup errors. With the included clear step-by-step guide, you remain fully in control of the process — whether you are conducting a simple observation of fungal growth for educational purposes, or engaging in the advanced study of special and exotic species.
Accessible Exploration By blending traditional cultivation knowledge with contemporary convenience, the Educational Grow Kit offers an accessible, intentional, and enjoyable way to explore the complexity of nature, without the usual hassle.
Mushroom spore shop
Educational Grow Kit – A Refined Approach to Mycology
The Educational Grow Kit, specialized Spore Syringes, and Spore Vials represent a professional evolution within the field of home botany. By combining scientific precision, ease of use, and high-quality substrates, this collection offers a structured and accessible option for those seeking to explore the fascinating lifecycle of rare and exotic fungal species.
Key Benefits of the Educational Grow Kit
An immersive and educational entry point into the world of mycology and botany
User-friendly all-in-one design optimized for consistent and successful growth
Flexible system suitable for researching a wide variety of standard and exotic strains
Offers full control over the cultivation process for guaranteed freshness and quality
Who we are
It all started with two guys who loved mushrooms. Since 2025, we have been creating the best natural mycelium experience by combining innovation and nature. Our signature product, the mycelium bar, also known as the magic bar or mushroom bar is designed to enhance perception in a natural and organic way. Based in the Netherlands, we believe true innovation grows from nature itself—allowing us to deliver authentic experiences without losing touch with our essence.


How it's made
Mycelium bars are grown, not made. Using carefully selected edible fungi and simple plant ingredients like grains and legumes, we let nature do the hard work. As the mycelium grows, it naturally binds the plants together, creating a firm, satisfying texture. The entire process takes place under controlled, food-safe conditions and is gently finished to ensure quality, safety, and great taste. The result is a nutritious, plant-based protein that’s minimally processed, sustainable, and surprisingly delicious. Curious how fungi turn plants into food? Discover how our mycelium bars come to life.
Who we are
It all started with two guys who loved hats.
How it's made
All of our products are sustainably made.